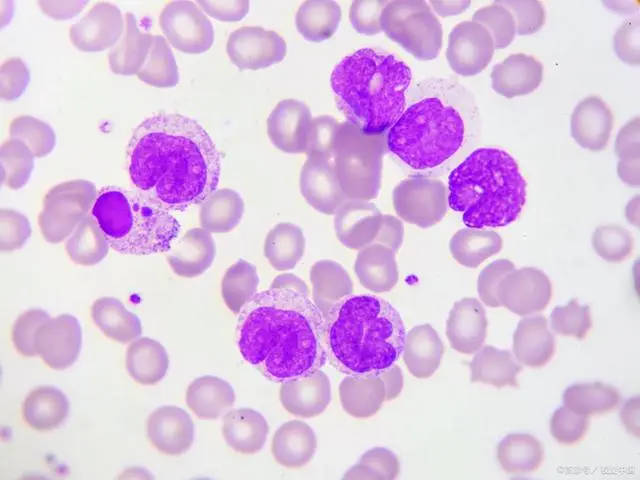
肺炎吃好得快的食物_肺炎吃好的蔬菜_得了肺炎吃什么好

得了肺炎吃什么好-肺炎患者的饮食攻略:药补不如食补,这些食物助你加速康复
时间:2024-08-25 来源:网络整理 人气:
哎呀呀,最近这肺炎闹得人心惶惶的,身体不舒服,胃口也不好,真是烦死人了!得了肺炎,除了乖乖听医生的话,好好吃药打针,咱们在吃的方面也得讲究讲究,毕竟“药补不如食补”嘛!

首先啊,得多吃点富含维生素C的东西,比如橙子、猕猴桃这些酸酸甜甜的水果,不仅好吃还能增强抵抗力。再来点鸡汤,这可是老祖宗传下来的好东西,炖得浓浓的,喝上一碗,暖胃又暖心。别忘了蔬菜,绿叶菜像菠菜、小白菜,清清淡淡,营养丰富,对身体恢复大有好处。

当然,也不能忘了蛋白质,鸡蛋、鱼肉、豆腐这些,都是优质蛋白的好来源,帮助修复身体,加速康复。还有啊,多喝水,保持水分充足,有助于排出体内的毒素,让身体更清爽。
总之呢,得了肺炎不要慌,合理饮食,配合治疗,咱们一定能快快好起来的!大家一起加油,战胜肺炎,恢复健康!

tokenpocket最新v1.8.7版下载:https://klbeyey.com/software/326.html
作者 克莱贝尔系统
相关推荐
教程资讯
教程资讯排行













